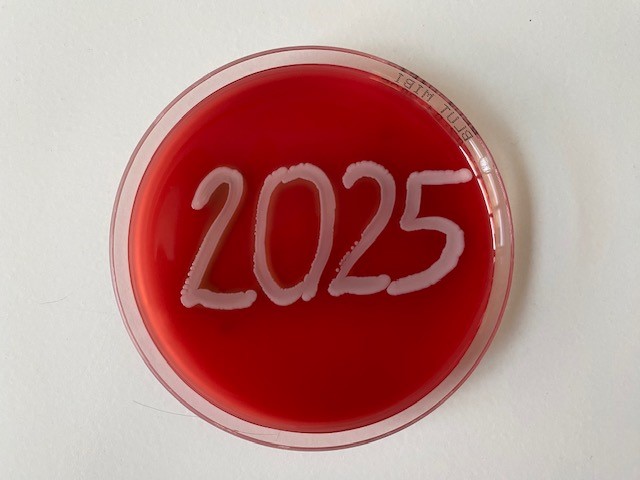

Wahlfach Vorklinik 2.-4. Fachsemester
Sommersemester 2025
- Trainer/in: Christian Jassoy
Semester: SoSe 2025
- Trainer/in: Philipp Blume
- Trainer/in: Susanne Kolbe-Busch
- Trainer/in: Susann Leupolt
- Trainer/in: Volha Rusinovich
- Trainer/in: Tiffany Schaumburg
Semester: SoSe 2025
- Trainer/in: Susann Leupolt
Semester: SoSe 2025
- Trainer/in: Claudia Claus
- Trainer/in: Mario Hönemann
- Trainer/in: Christian Jassoy
- Trainer/in: Susann Leupolt
- Trainer/in: Melanie Maier
- Trainer/in: Anne Mlocek
- Trainer/in: Corinna Pietsch
Semester: SoSe 2025
- Trainer/in: Nadine Dietze
- Trainer/in: Ines Eder
- Trainer/in: Annett Hennig-Rolle
- Trainer/in: Judith Kikhney
- Trainer/in: Susann Leupolt
- Trainer/in: Norman Lippmann
- Trainer/in: Anne Mlocek
- Trainer/in: Lisa Müller
- Trainer/in: Maike Rebenstorff
- Trainer/in: Catalina Suzana Stingu
Semester: SoSe 2025
- Trainer/in: Susann Leupolt
Semester: SoSe 2023

- Trainer/in: Claudia Claus
- Trainer/in: Nadine Dietze
- Trainer/in: Christian Jassoy
- Trainer/in: Susann Leupolt
- Trainer/in: Norman Lippmann
- Trainer/in: Melanie Maier
- Trainer/in: Maike Rebenstorff
- Trainer/in: Catalina Suzana Stingu
Semester: SoSe 2023